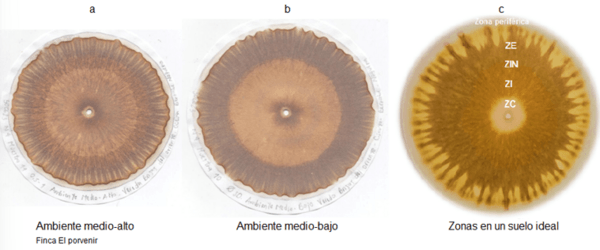
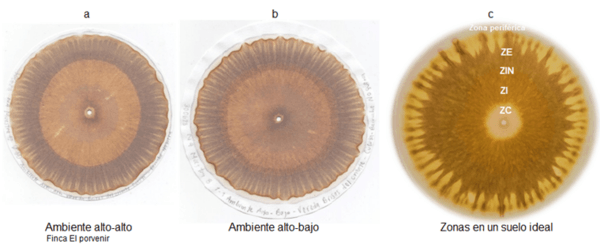

INTRODUCCION
La producción arrocera en el distrito de riego del rio Zulia ha venido en los últimos 5 años con tendencia a la reducción en cerca de una tonelada por hectárea por diversos factores relacionados con los recursos disponibles para la producción del grano. Entre ellos la pérdida del balance ideal del suelo compuesta por la fase mineral, la fase orgánica y los microorganismos; el suelo está formado en un 50% de material sólido y un 50% de poros, estos poros pueden ser llenos de aire o de agua. La inundación permanente, el uso de altas láminas de agua, el aumento de la temperatura del agua y la erosión, causada por el lavado deterioran la capacidad productiva.
Se pretende con este aporte implementar y evaluar la cromatografía como una técnica sencilla, practica, de bajo costo y confiable emplearla como herramienta de diagnóstico para mejorar las condiciones de producción en nuestras fincas.
2. ESTADO DEL ARTE
Son diversos los métodos empleados para determinar los contenidos y la calidad del suelo, algunos de los cuales buscan la implementación de prácticas de manejo, conservación y sostenibilidad a través de programas como el AMTEC. Una de estas alternativas dentro de la agricultura biodinámica es la cromatografía de Pfeiffer (CPF) o cromatografía en papel circular plano, que puede ser aplicado para el análisis integral de la calidad de los suelos, compostas y biofertilizantes (Khemani et al., 2008). Keulemans define a la cromatografía como un “método de separación en el que los componentes a desglosar se distribuyen entre dos fases, una de las cuales constituye un lecho estacionario de amplio desarrollo superficial y la otra es un fluido que pasa a través o a lo largo del lecho estacionario” (Silva & García, 2006)., (Muñoz & Túnez, 2004).
La cromatografía de Pfeiffer es una técnica sencilla, rápida y de bajo costo, de análisis cualitativo para determinar las condiciones de un suelo (Medina et al., 2018; Antunes de Melo et al., 2019; Costa y Tavarez, 2019), a través de un cromatograma (Gordillo et al., 2011) cuya descripción se hace con base en sus componentes: tamaño, forma y colores revelados. En él se observan anillos denominados zonas, en que se reconocen cuatro: zona central (ZC), zona interna (ZI), zona intermedia (ZIN) y zona externa (ZE). El aspecto de estas zonas muestra la transformación de la materia orgánica y el proceso de humificación (Restrepo y Pinheiro, 2011; Domingues et al., 2018). Además, están los radiales (RAD) que son indicadores del proceso de descomposición de minerales (Heredia, 2012); las nubes (NN) que se muestran como explosiones o manchas en la zona externa, y los hoyos, representados por pequeños orificios en las zonas interna e intermedia, indicadores ambos, de actividad enzimática o actividad biológica. En un suelo dañado, por el contrario, las diferentes zonas se muestran claramente divididas y aisladas unas de otras. En cuento a los colores, los cromatogramas de suelos sanos son de tonos amarillos, dorados, anaranjados, rojizos o cafés claros; mientras que en suelos destruidos o contaminados, tenemos colores oscuros, negros, grises y verdes oscuros. (Restrepo y Pinheiro, 2015).
3. OBJETIVOS
3.1 Objetivo general
Determinar mediante cromatografía de Pfeiffer el estado actual del balance mineral, orgánico y biológico de los suelos en algunas fincas arroceras y generar recomendaciones de manejo
3.2 Objetivos específicos
3.2.1 Interpretar las cromatografías para establecer el balance Mineral, Materia orgánica y Microbiológico de los suelos arroceros en tres fincas bajo la producción por ambientes.
3.2.2. Correlacionar los resultados de las cromatografías con los resultados de análisis de suelos y microbiológicos por finca.
3.2.3 Proponer recomendaciones de manejo para mejorar las condiciones de vida del suelo para la mejora de la producción.
4. MATERIALES Y MÉTODOS
4.1. Materiales. Muestras de suelos, papel Whatman 4, Nitrato de plata (AgNO3), hidróxido de sodio (NaOH), enlermeyer, morteros, tamiz, muestras de suelo, herramientas.
4.2. METODOLOGIA
4.2.1.Muestreo de suelos para cromatografías.
Se seleccionaron tres fincas con más de 40 años de producción de arroz: Finca Los Caños en la vereda Los Caños y Finca Quitilandia en la vereda Pueblitos en el municipio de El Zulia, y la Finca El Porvenir en la vereda Brisas del Oriente en el Municipio de Cúcuta, departamento de Norte de Santander (Colombia); se determinó el área y de acuerdo con el historial proporcionado por el productor, se dividió por ambientes Alto, Medio y Bajo por la producción de los últimos 5 años. La investigación se realizó entre los meses de marzo a octubre del año 2023. El muestreo total correspondió a tres fincas, por tres ambientes por dos condiciones de producción para un total de 18 muestras para el análisis por cromatografía.
4.2.2.Muestreo para análisis químico y microbiológico del suelo.
Se tomo muestras de suelos de un kilogramo para análisis físico químico por ambientes principales y sub ambientes a 20 cm de profundidad, siguiendo las recomendaciones de muestreo respectivas; enviados al laboratorio de Agrosavia. De igual manera para los análisis microbiológicos se tomaron 500 gramos de suelos por ambientes y enviados al laboratorio de fitopatología del Centro Experimental Santa Rosa Fedearroz FNA.
4.2.3. Procedimiento para la elaboración de las cromatografías. Los suelos fueron analizados mediante la cromatografía de Pfeiffer (CPF) o cromatografía en papel circular plano de acuerdo con lo descrito por Restrepo y Pinheiro (2011)
4.2.4 Interpretación de las cromatografías
La valoración de los componentes del cromatograma se realizó midiendo manualmente el espesor de cada zona: ZC, ZI, ZIN y ZE (Restrepo y Pinheiro, 2011) mediante el uso de un calibrador Vernier Digital. Se contabilizó el número de nubes NN a lo largo de toda la circunferencia de la ZE y el número de los radianes RAD presentes en ángulo de 90°. La zona central ZC es la vía de entrada por donde todas las sustancias que se analizan circulan por el fenómeno de capilaridad. Es la zona de aireación u oxigenación, donde se determina la compactación y el uso de fertilizantes. La zona interna ZI llamada zona mineral, en ella se concentra la mayoría de las reacciones con los minerales de la muestra. La zona intermedia ZIN se le denomina zona proteica o de la materia orgánica, y la zona externa ZE o zona enzimática o nutricional determina la presencia de los microorganismos. Figura 1.
Figura 1. Esquema de las principales zonas de un cromatograma
Para la interpretación de los cromas se tuvo como referencia la sugerida por Restrepo y Pinheiro, 2015 de un croma realizado en un suelo ideal en la cual la zona central ZC presenta una coloración blanca cremosa que se desvanece suavemente y se integra a la zona interna o mineral ZI, y continua de forma armónica, sin interrupciones hacia la zona proteica o de la materia orgánica ZIN, y la zona enzimática ZE que se encuentra al final de la figura del croma. Esto es un indicador de un excelente suelo, con buena reserva de materia orgánica, plena actividad microbiológica integrada y diversa, sin ningún signo de compactación y buena estructura aireada. Figura 2.
Figura 2. Cromatografía en un suelo ideal en equilibrio de las MMM
5. RESULTADOS Y DISCUSIÓN
Es poca la información sobre la técnica de cromatografías en suelos arroceros para diagnosticar, planificar y entender el balance entre las partes Mineral, Materia orgánica y Microorganismos (MMM). Cada vez se hace más importante cambiar las estrategias de nutrición para que no se dependa tan solo de la química para obtener las cosechas.
5.1 Cromatografías por ambientes en las fincas arroceras.
Los ambientes se determinaron por rendimientos altos, medios y bajos basados en los resultados de las cosechas de los últimos cinco años con base en la experiencia de los propietarios de las fincas. Figura 3.
Figura 3. Caracterización de las fincas por ambientes de producción
5.1.1 Finca Los Caños.
Ubicada en el municipio El Zulia coordenadas 8,171051N, -72,552463 W con una extensión de 7 has. Los rangos de rendimientos para el ambiente alto oscilaron 6450 a 6860 kg. Ha-1, ambiente medio entre 5800 a 6400 kg. Ha-1 y ambiente bajo entre 4500 y 5600 kg. Ha-1. Entre los limitantes agronómicos de la producción se encuentra altas infestaciones de arroz maleza conformada por 6 ecotipos adaptados y de alta competitividad.
5.1.1.1 Ambiente alto. El ambiente alto se caracteriza por presentar suelo con estructura liviana, asociadas a las prácticas implementadas en el cultivo establecido (tipo de suelo, saturación hídrica requerida). Se analizaron los cromas en dos sitios con mayor rendimiento (alto-alto) y menor rendimiento (alto-bajo) como aparece en la figura 4 a y b, y se compararon con el croma de un suelo ideal figura 4 c. Se observan diferencias marcadas para los ambientes altos, en el tamaño de la zona central (ZC) es menor en el alto-bajo, con tonalidades más oscuras en la zona intermedia (ZI); también hay diferencias en el tamaño de la zona central (ZC) siendo menor en el alto-bajo, con tonalidades más oscuras en la zona intermedia (ZI). Figura 4b.
Figura 4. Cromatografías ambientes alto de producción (a y b), comparadas con la de un suelo ideal (c)
5.1.1.2 Ambiente Medio. En el medio alto (m-a) estructura pesada, baja disponibilidad e integración de sus minerales, baja disponibilidad de la materia orgánica existente y ausencia de material orgánico de reserva, inexistente actividad microbiológica, lo cual da como resultado un suelo en desequilibrio Figura 5 a. El ambiente medio bajo (m-b) estructura semi liviana, media – alta disponibilidad e integración de sus minerales, media disponibilidad de la materia orgánica existente y poca evidencia de material orgánico de reserva, además muy baja actividad microbiológica. Figura 5b; el suelo ideal presenta buena definición de sus zonas Figura 5c.
Figura 5. Cromatografías ambientes medio de producción (a, b), comparadas con la de un suelo ideal (c)
5.1.1.3 Ambiente Bajo. Para el ambiente bajo-alto: textura semi liviana, media a alta disponibilidad e integración de sus minerales, media disponibilidad de la materia orgánica existente y baja evidencia de material orgánico de reserva y baja actividad microbiológica. Figura 6a. Para el ambiente bajo-bajo medias condiciones de estructura, cuenta con una media disponibilidad e integración de sus minerales, media – alta disponibilidad de la materia orgánica existente y baja cantidad de material orgánico de reserva, además de una baja actividad microbiológica. Figura 6b.
Figura 6. Cromatografías ambientes bajos de producción (a, b), comparadas con la de un suelo ideal (c).
Aspectos importantes en la interpretación de los cromas de la finca Los Caños se mencionan a continuación Tabla 1.
Tabla 1. Descripción de las características de los cromatogramas por ambientes finca Los Caños:
5.1.1.4. Análisis físico, químico y microbiológico. Los resultados permiten comparar parámetros y valores con las lecturas en los cromatogramas. Con buena interpretación de los cromas se logra alta confiabilidad en el diagnostico. Se corroboran aspectos de física del suelo como la textura de tipo arcillosa, la materia orgánica se muestra baja y baja reserva según el croma. Hay diferencias entre ambientes entre sus componentes, no obstante, la disponibilidad también va a depender de la acción microbiana; para todos los ambientes la capacidad de intercambio catiónico es baja. Tabla 2.
Tabla 2. Resultados de análisis de suelos por ambientes de producción, finca Los Caños.
Las cromatografías describen una baja actividad microbiana y en los análisis se observan relaciones en algunos casos directas, entre presencia de microorganismos y ambientes de producción, pero en otros distinta; lo cual se explica, que el equilibrio entre lo mineral, la materia orgánica y los microorganismos es fundamental. Tabla 3.
Tabla 3. Resultados de análisis microbiológicos por ambientes, finca Los Caños
5.1.2. Finca El Porvenir.
Ubicada en la vereda Brisas del Oriente del municipio de Cúcuta, coordenadas 7,978817°N, -72,590244° W con una extensión de 8 has. Los rangos de rendimientos para el ambiente alto oscilaron entre 6950 a 6800 kg. Ha-1, ambiente medio entre 6700 a 6300. Ha-1 y ambiente bajo entre 5800 y 6200 kg. Ha-1.
5.1.2.1 Ambiente alto. En este ambiente se tomaron dos sitios el de mayor registro de producción alto- alto (a-a) y el de menor registro de producción alto bajo (a-b), se analizaron los cromas mayores rendimientos (alto-alto) y menores rendimientos (alto-bajo) y se compararon con un suelo ideal figura 7.
 Figura 7
Figura 7. Cromatografías ambientes alto de producción (a y b), comparadas con la de un suelo ideal (c)
5.1.2.2 Ambiente Medio. Corresponde a los rendimientos medios de la finca Los Caños, se analizaron los cromas en dos sitios con rendimientos medios altos (m-a) y rendimientos medios bajos (m-b) figura 8 a y b, comparados con el croma de un suelo ideal en las proporciones MMM, figura 8c.
 Figura 8.
Figura 8. Cromatografías ambientes medio de producción (a, b), comparadas con un suelo ideal (c), finca el Porvenir
5.1.2.3 Ambiente Bajo. Seleccionado por registrar los valores más bajos de rendimiento, se analizaron dos áreas correspondientes a rendimientos bajos- altos (b-a) y rendimientos bajos-bajos (b-b)., los cromas se compararon con los resultados de un suelo en equilibrio. Figura 9.
Figura 9. Cromatografías ambientes bajos de producción (a, b), comparadas con la de un suelo ideal (c).
Aspectos importantes en la interpretación de los cromas se describen a continuación. (Tabla 4).
Tabla 4. Descripción de las características de los cromatogramas por ambientes finca El Porvenir.
5.1.2.4. Análisis físico, químico y microbiológico.
La cromatografía presenta grado de integración y ramificación media a baja de la zona mineral, coincide en la clase textural, baja reserva de materia orgánica con clase textural liviana que corresponde a franco arenosos en el análisis de suelos. Tabla 5.
Tabla 5. Resultados de análisis de suelos por ambientes de producción, finca El Porvenir.
Se muestran contenidos de microorganismos variables por ambientes y en muchos casos son colonias de supervivencia que se mantienen en el suelo a presar de las prácticas de manejo del cultivo. Es necesario reactivar y repoblar estos microorganismos, mejorando su condición mediante la adición de materia orgánica o aplicaciones de consorcios microbianos. Tabla 6
Tabla 6. Análisis microbiológico por ambientes de producción finca El Porvenir.
5.1.3 Finca Quitilandia.
Ubicada en el municipio de El Zulia en la vereda Pueblitos en la margen izquierda del distrito de riego del río Zulia 8,127745° -72,552463°. La extensión del cultivo del arroz es de 15 has durante los últimos 30 años. El sistema de riego es por melgas y se realizan 2 cosechas de arroz por año. Para los análisis diagnósticos mediante cromatografías se elaboró el plano teniendo en cuenta los históricos de rendimiento suministrados por el productor y representado por colores en el plano. Figura 3.
5.1.3.1 Ambiente alto. Este ambiente presenta registro de producción entre 6800 y 7200 kg. ha -1 en un área de 6,2 has (color verde) figura 10. Las variaciones de rendimiento se establecieron como alto-alto y alto- bajo y de igual manera el muestreo.
Figura 10. Cromatografías ambientes alto de producción (a y b), comparadas con la de un suelo ideal (c)
La zona central del croma muestra tono beige con borde café oscuro, no se evidencia presencia de nitrógeno; estructura pesada, de naturaleza arcillosa, con alta capacidad de retención de humedad. Con zona mineral de media a baja ramificación y ausencia de materia orgánica. Tabla 3.
5.1.3.2 Ambiente medio. Registra históricos de rendimiento entre 5800 y 6700 kg.ha-1 y su extensión es de 5,8 has (figura 11), de igual manera se analizaron los contenidos en las cromatografías para los ambientes medio-alto y medio-bajo.
Figura 11. Cromatografías ambientes medio de producción (a y b), comparadas con la de un suelo ideal (c)
Zona central casi inexistente, de tono marrón oscuro con borde negro grisáceo (figura 11a) y tono beige con borde café oscuro (figura 11b), Suelo de estructura pesada, de naturaleza arcillosa, con alta capacidad de retención de humedad. Ausencia de materia orgánica; no presencia de nitrógeno.
5.1.3.3 Ambiente bajo. Con rendimientos entre4800 y 5700 kg.ha -1 suelos más deficientes en su fertilidad , bajo crecimiento de las plantas y mayor presencia de malezas, tiene una extensión de 3 has (figura 12). Las diferencias dentro del mismo ambiente son marcadas y están ligadas directamente al rendimiento.
Figura 12. Cromatografías ambientes bajo de producción (a y b), comparadas con suelo ideal (c)
La descripción de características de cada zona del cromatograma se describe a continuación (Tabla 3):
Tabla 7. Descripción de las características de los cromatogramas por ambientes finca Quitilandia.
5.1.2.5. Análisis físico, químico y microbiológico.
Los cromas muestran en la zona mineral (ZI)una textura semipesado (a-a) a pesada ( (m-a) estructura semipesado arcilloso (a-b) con alta capacidad de retención de humedad, que concuerda con el resultado del laboratorio con clase textural Franco arcilloso (Tabla 7). La acidez, los contenidos de materia orgánica es variable entre ambientes y según el croma en el ambiente alto, con disponibilidad media en (a-a) y (a-b), en el ambiente medio baja disponibilidad en el suelo (m-a) y media en (m-b).Ambiente bajo con media disponibilidad de materia orgánica en este suelo(b-a) y (b-b). y baja capacidad de intercambio catiónico. Tabla 8
Tabla 8. Resultados de análisis de suelos por ambientes de producción, finca Quitilandia.
Estos resultados nos invitan a escuchar el llamado a la conservación del suelo, a entender la importancia del equilibrio y a olvidarnos que la solución tan solo no está en un bulto de una fuente de fertilizante, sino en la interacción de los componentes del suelo. Tabla 9.
Tabla 9. Resultados de análisis microbiológicos de suelos por ambientes de producción, finca Quitilandia.
Tanto los cromas como los análisis microbiológicos de la finca presentan baja presencia de actividad microbiológica – enzimática en los ambientes. Debemos darle al suelo las condiciones ideales para que los microorganismos se expresen sus funciones, y no tan solo que se estén defendiendo para subsistir por efecto de malas prácticas de manejo.
5.2. DIAGNOSTICO GENERAL DE LOS SUELOS
Suelo con condiciones de estructura liviana a pesada asociadas a las prácticas implementadas en el cultivo establecido, suelos adesados sometidos a batidos frecuentes, cuenta con una media a baja disponibilidad e integración de sus minerales, media – alta disponibilidad de la materia orgánica existente y bajo nivel de material orgánico de reserva, además de una baja actividad microbiológica, lo cual da como resultado un suelo que presenta desequilibrios que repercuten en el desarrollo del cultivo. Ninguna variedad con genética de alta productividad frente a estas condiciones puede expresar su potencial de rendimiento,
5.3. RECOMENDACIONES DE MANEJO.
Estamos ante una situación crítica del estado de los suelos en las tres fincas analizadas. Los suelos han sido explotados durante muchos años. Las practicas intensivas y repetitivas de una misma labor los han deteriorado en cada cosecha, por eso, es urgente recuperar el potencial productivo; devolverle su fertilidad, su vida y sus características y eso depende de la responsabilidad y la voluntad de quien lo utiliza.
La remediación es la tarea urgente por hacer; mencionemos algunos aspectos importantes para tal fin:
.- Realizar análisis físicos, químicos y microbiológicos por ambientes para tomar decisiones de manejo del suelo para el cultivo del arroz o de rotación.
.- Evitar el batido en la preparación o la inundación permanente en el cultivo del arroz.
.- En la inundación permanente se calienta el agua y la planta no se puede alimentar bien, se reduce su macollamiento, su altura y producción.
.- Incorporar o formar cobertura con los coproductos (tamo del arroz) como fuente de materia orgánica, debe ser aplicados con microorganismos y darles un tiempo de degradación antes del laboreo.
.- NO quemar el tamo, esto produce contaminantes orgánicos persistentes (COP).
.- Adicione materia orgánica con frecuencia, busque fuentes locales de calidad.
.- En la nutrición interaccionar fuentes orgánicas con fuentes químicas.
.- Aumentar la retención de humedad del suelo y evitar el abuso con el agua.
.- Hacer seguimientos periódicos del estado del suelo con análisis específicos.
.- Utilizar los consorcios microbianos en lo posible y restar carga química contaminante del suelo.
.- Utilizar solubilizadores de fósforo, micorrizas, fijadores de nitrógeno. Para problemas fitosanitarios hongos y bacterias que eliminan los patógenos,
.- Descontaminar los suelos de los propágulos de malezas agresivos con el cultivo.
.- Nutrir siempre con base a las necesidades de cada variedad, aplicar por ambientes y fraccionar.
.- Nunca abone tarde. hágalo desde muy temprano para garantizar el potencial de producción.
.- Cuando fertilice, corrija de inmediato los errores de aplicación.
.- Planifique el cultivo con base en las condiciones ambientales, consulte los pronósticos climáticos.
CONCLUSIONES
Las cromatografías forman parte del diagnostico rápido del estado del sistema productivo, su correcta interpretación permite diagnosticar correctamente los escenarios de producción y concuerdan en alto porcentaje con los resultados obtenidos en los análisis del suelo.
Se evidencia la relación entre los resultados de cromatografías y los análisis por laboratorio, lo cual indica que las cromatografías pueden de forma más rápida dar una información cualitativa del suelo.
Se evidencia que la baja producción, las diferencias de producción por ambientes y los manejos iguales repetitivos del cultivo son parte de la causa del bajo potencial de productividad.
A pesar de ser zonas muy importantes, bien ubicadas, con recursos disponibles, áreas pequeñas y adecuadas sus suelos no han sido bien tratados y es urgente su recuperación.
Evitarse las preparaciones frecuentes o el sobre laboreo, adicionar materia orgánica y microrganismos, usar menos agua, nutrir oportunamente y sembrar semilla certificada, potencializan la producción. A mayor agronomía mayor inversión.